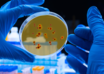

True long COVID risk likely 'exaggerated', says global study
IANS | Sep 27, 2023
DEN-2 variant in dengue is more prevalent
IANS | Sep 27, 2023
Your omega 3 fish oil pills may be rancid, unhealthy: Study
IANS | Sep 26, 2023
Scientists find genetic code behind rare kidney cancer
IANS | Sep 26, 2023
Stem cell therapy shows promise for reducing signs of Alzheimer's
IANS | Sep 26, 2023
Genetics may signal risk of hard to find ovarian cancer: Experts
IANS | Sep 26, 2023
Adults with intellectual disabilities are at risk for dementia
ANI | Sep 26, 2023
Rare gene variants causing hereditary hair loss in men identified
IANS | Sep 25, 2023
Most read this week